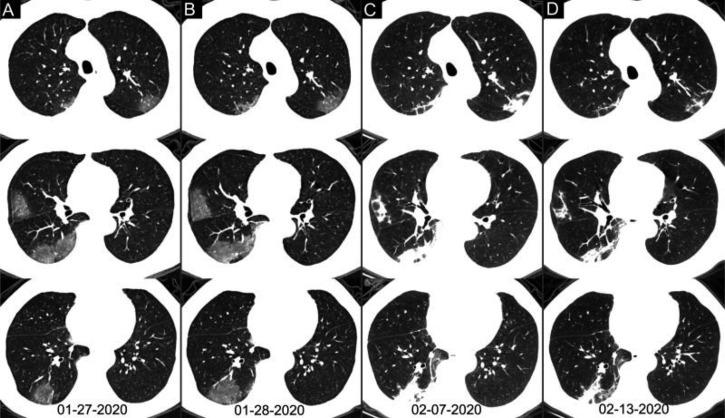
https://cdn.ncbi.nlm.nih.gov/pmc/blobs/e46b/7233399/535f7a79954a/radiol.2020200642.fig5.jpg

中国 2019 年冠状病毒病(COVID-19)的胸部 CT 与 RT-PCR 检测的相关性:1014 例报告。
Correlation of Chest CT and RT-PCR Testing for Coronavirus Disease 2019 (COVID-19) in China: A Report of 1014 Cases.
机构信息
From the Departments of Radiology (T.A., Z.Y., C.Z., C.C., L.X.) and Laboratory Medicine (H.H., Z.S.), Tongji Hospital, Tongji Medical College, Huazhong University of Science and Technology, 1095 Jiefang Ave, Qiaokou District, Wuhan, Hubei 430030, China; Department of Artificial Intelligence, Julei Technology Company, Wuhan, China (W.L.); and Division of Imaging Processing, Department of Radiology, Leiden University Medical Center, Leiden, the Netherlands (Q.T.).
出版信息
Radiology. 2020 Aug;296(2):E32-E40. doi: 10.1148/radiol.2020200642. Epub 2020 Feb 26.
Background Chest CT is used in the diagnosis of coronavirus disease 2019 (COVID-19) and is an important complement to reverse-transcription polymerase chain reaction (RT-PCR) tests. Purpose To investigate the diagnostic value and consistency of chest CT as compared with RT-PCR assay in COVID-19. Materials and Methods This study included 1014 patients in Wuhan, China, who underwent both chest CT and RT-PCR tests between January 6 and February 6, 2020. With use of RT-PCR as the reference standard, the performance of chest CT in the diagnosis of COVID-19 was assessed. In addition, for patients with multiple RT-PCR assays, the dynamic conversion of RT-PCR results (negative to positive, positive to negative) was analyzed as compared with serial chest CT scans for those with a time interval between RT-PCR tests of 4 days or more. Results Of the 1014 patients, 601 of 1014 (59%) had positive RT-PCR results and 888 of 1014 (88%) had positive chest CT scans. The sensitivity of chest CT in suggesting COVID-19 was 97% (95% confidence interval: 95%, 98%; 580 of 601 patients) based on positive RT-PCR results. In the 413 patients with negative RT-PCR results, 308 of 413 (75%) had positive chest CT findings. Of those 308 patients, 48% (103 of 308) were considered as highly likely cases and 33% (103 of 308) as probable cases. At analysis of serial RT-PCR assays and CT scans, the mean interval between the initial negative to positive RT-PCR results was 5.1 days ± 1.5; the mean interval between initial positive to subsequent negative RT-PCR results was 6.9 days ± 2.3. Of the 1014 patients, 60% (34 of 57) to 93% (14 of 15) had initial positive CT scans consistent with COVID-19 before (or parallel to) the initial positive RT-PCR results. Twenty-four of 57 patients (42%) showed improvement on follow-up chest CT scans before the RT-PCR results turned negative. Conclusion Chest CT has a high sensitivity for diagnosis of coronavirus disease 2019 (COVID-19). Chest CT may be considered as a primary tool for the current COVID-19 detection in epidemic areas. © RSNA, 2020 ترجمه چکیده این مقاله به فارسی، در ضمیمه موجود است.
背景 胸部 CT 用于 2019 年冠状病毒病(COVID-19)的诊断,是逆转录聚合酶链反应(RT-PCR)检测的重要补充。目的 探讨胸部 CT 与 RT-PCR 检测在 COVID-19 诊断中的诊断价值和一致性。材料与方法 本研究纳入 2020 年 1 月 6 日至 2 月 6 日期间在中国武汉接受胸部 CT 和 RT-PCR 检测的 1014 例患者。以 RT-PCR 为参考标准,评估胸部 CT 对 COVID-19 的诊断性能。此外,对于多次 RT-PCR 检测的患者,分析 RT-PCR 结果(从阴性转为阳性,从阳性转为阴性)的动态转换与 RT-PCR 检测间隔为 4 天或更长时间的系列胸部 CT 扫描的一致性。结果 1014 例患者中,601 例(60%)的 RT-PCR 检测结果为阳性,888 例(88%)的胸部 CT 扫描结果为阳性。基于阳性 RT-PCR 检测结果,胸部 CT 提示 COVID-19 的敏感度为 97%(95%置信区间:95%,98%;601 例患者中的 580 例)。在 413 例 RT-PCR 检测结果为阴性的患者中,308 例(75%)的胸部 CT 检查结果为阳性。在这 308 例患者中,48%(308 例中的 103 例)被认为是高度疑似病例,33%(308 例中的 103 例)为可能病例。在对系列 RT-PCR 检测和 CT 扫描的分析中,初始阴性到阳性 RT-PCR 结果之间的平均间隔为 5.1 天±1.5;初始阳性到随后的阴性 RT-PCR 结果之间的平均间隔为 6.9 天±2.3。在 1014 例患者中,60%(57 例中的 34 例)至 93%(15 例中的 14 例)在初始阳性 RT-PCR 结果之前(或同时)有与 COVID-19 一致的初始阳性 CT 扫描。在 RT-PCR 结果转为阴性之前,24 例(42%)患者的随访胸部 CT 扫描显示改善。结论 胸部 CT 对 2019 年冠状病毒病(COVID-19)的诊断具有较高的敏感度。胸部 CT 可作为当前 COVID-19 检测在疫区的主要工具。 ©RSNA,2020